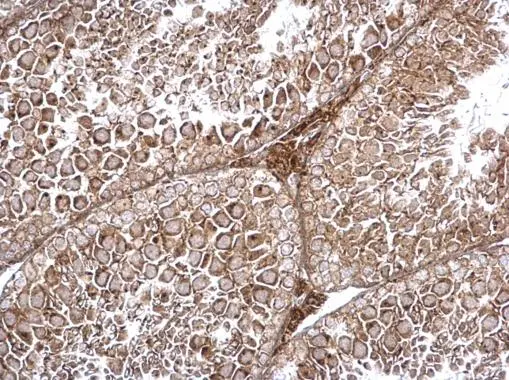
TRAPPC2L antibody detects TRAPPC2L protein at cytosol on mouse testis by immunohistochemical analysis. Sample: Paraffin-embedded mouse testis. TRAPPC2L antibody (GTX120259) dilution: 1:500. 
 Antigen Retrieval: Trilogy? (EDTA based, pH 8.0) buffer, 15min

TRAPPC2L antibody detects TRAPPC2L protein at cytosol on mouse hind brain by immunohistochemical analysis. Sample: Paraffin-embedded mouse hind brain. TRAPPC2L antibody (GTX120259) dilution: 1:500.
Antigen Retrieval: Trilogy? (EDTA based, pH 8.0) buffer, 15min
TRAPPC2L antibody
GTX120259
ApplicationsWestern Blot, ImmunoHistoChemistry, ImmunoHistoChemistry Paraffin
Product group Antibodies
ReactivityHuman, Mouse
TargetTRAPPC2L
Overview
- SupplierGeneTex
- Product NameTRAPPC2L antibody
- Delivery Days Customer9
- Application Supplier NoteWB: 1:500-1:3000. IHC-P: 1:100-1:1000. *Optimal dilutions/concentrations should be determined by the researcher.Not tested in other applications.
- ApplicationsWestern Blot, ImmunoHistoChemistry, ImmunoHistoChemistry Paraffin
- CertificationResearch Use Only
- ClonalityPolyclonal
- Concentration0.74 mg/ml
- ConjugateUnconjugated
- Gene ID51693
- Target nameTRAPPC2L
- Target descriptiontrafficking protein particle complex subunit 2L
- Target synonymsHSPC176, PERRB, trafficking protein particle complex subunit 2-like protein, hematopoietic stem/progenitor cells 176, trafficking protein particle complex 2 like
- HostRabbit
- IsotypeIgG
- Protein IDQ9UL33
- Protein NameTrafficking protein particle complex subunit 2-like protein
- Scientific DescriptionMay play a role in vesicular transport from endoplasmic reticulum to Golgi.
- ReactivityHuman, Mouse
- Storage Instruction-20°C or -80°C,2°C to 8°C
- UNSPSC41116161